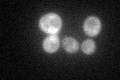
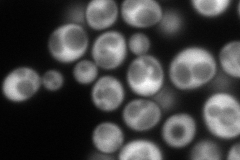
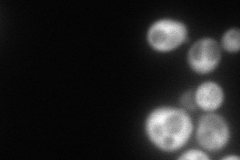
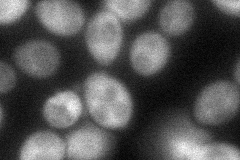
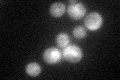

View description
Alpha subunit of cytoplasmic phenylalanyl-tRNA synthetase, forms a tetramer with Frs1p to form active enzyme; evolutionarily distant from mitochondrial phenylalanyl-tRNA synthetase based on protein sequence, but substrate binding is similar
Localization:
Intensity:
Fold change:
Significance:
-
C’ GFP library in SD
cytosol63.53 -
N' NOP1pr-GFP in SD
cytosol315.552 -
N' TEF2pr-mCherry in SD
cytosol172.034 -
N' NATIVEpr-GFP in SD

missing0 -
N' TEF2pr-VC and Cyto-VN in SD
cytosol59.9766 -
C’ GFP library in SD+DTT

cytosol97.511.53Yes -
C’ GFP library in SD+H2O2

cytosol71.611.12No -
C’ GFP library in Starvation Media
cytosol61.010.96No -
C’ GFP library on the background of Pup2-DaMP

cytosol -
C’ GFP library on the background of CCT mutant

cytosol76.22511.19971No
